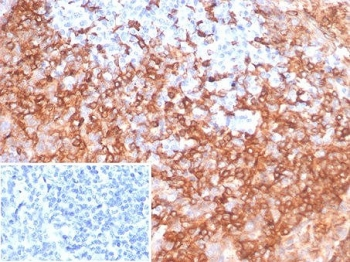
HLA-DRB Antibody

You have no items in your shopping cart.
- Featured

IF, IHC
Human
Recombinant
Unconjugated
1 panel - Featured

IF, IHC
Human
Recombinant
Unconjugated
1 panel - Featured

IF, IHC
Human
Recombinant
Unconjugated
1 panel - Featured

Greater than 90% as determined by SDS-PAGE.
18.2 kDa
E.coli
1 mg, 20 μg, 100 μg - Featured

Greater than 90% as determined by SDS-PAGE.
39.6 kDa
Mammalian cell
20 μg, 100 μg, 1 mg